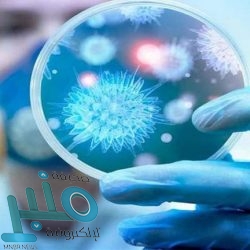
برشلونة يبلغ راكيتيتش بالرحيل

كشفت صحيفة ”سبورت“ الكتالونية عن أن برشلونة أبلغ لاعبه الكرواتي إيفان راكيتيتش ببيعه خلال فترة الانتقالات الصيفية المقبلة.
وانتشرت شائعات بشأن رحيل راكيتيتش عن برشلونة منذ فترة طويلة لكن عقب وصول الهولندي فرينكي دي يونغ قادما من أياكس أمستردام وتوقيع سيرجيو بوسكيتس (31 عاما) على عقد يمتد لخمس سنوات، بدا خط وسط برشلونة مزدحما بعض الشيء ويبدو أن اللاعب الكرواتي الأقرب للرحيل.
وتلقى راكيتيتش العديد من العروض خلال الأعوام الماضية أبرزها من باريس سان جيرمان وإنتر ميلان لكنه تمسك بالبقاء في النادي الكتالوني.
وأضافت الصحيفة على غلاف عددها الصادر غدا الاثنين أن برشلونة أبلغ اللاعب بوجود ثلاثة عروض من إيطاليا يراها النادي إيجابية لكن راكيتيتش يعطي الأولوية للعودة إلى ناديه السابق اشبيلية لأنه لا يريد الرحيل عن إسبانيا.
ولم تكشف الصحيفة عن العروض الإيطالية لكنها بالتأكيد لن تخرج عن ميلان وإنتر ويوفنتوس والأندية الثلاثة سعت من قبل خلف راكيتيتش.
ويتوقف الليغا حاليا بسبب انتشار فيروس كورونا ومن غير المتوقع عودته قريبا لكن بمجرد فتح فترة الانتقالات الصيفية سيرحل راكيتيتش عن برشلونة.
وتعاني الأندية من مشاكل مالية واقتصادية خاصة برشلونة التي خفض أجور لاعبيه بنسب كبيرة نظرا لتوقف النشاط الرياضي منذ الشهر الماي بسبب فيروس كورونا.